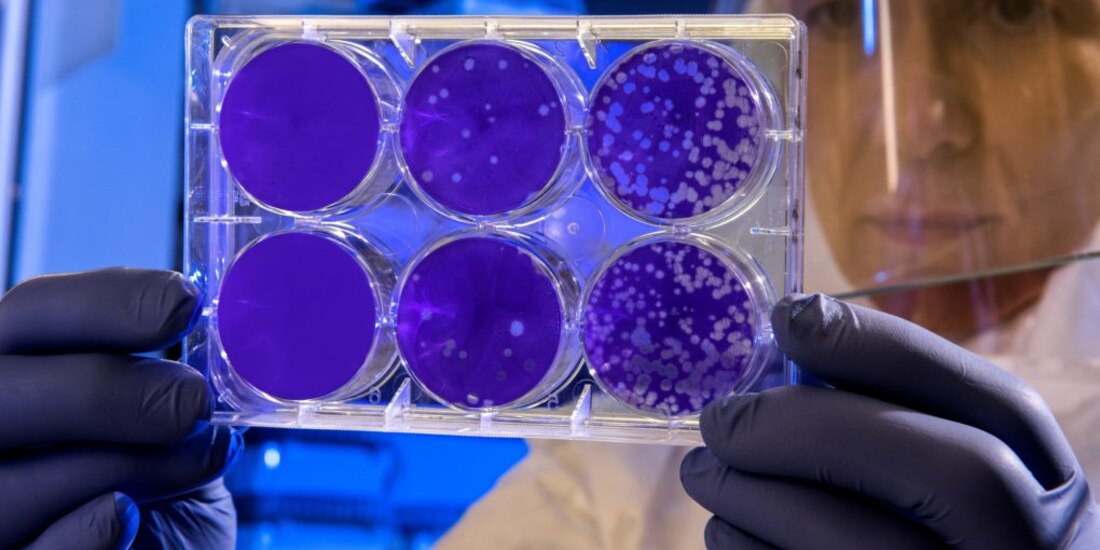
5ece22c8a7233.jpeg

La Organización Mundial de la Salud (OMS) dijo hoy que el coronavirus 2019-nCoV aún no ha desatado una “pandemia”, término que se aplica en una situación de propagación global de una enfermedad, ya que África y América Latina carecen de casos confirmados.
"Actualmente, no estamos en una situación de pandemia [...] estamos en una fase epidémica con brotes múltiples", dijo Sylvie Briand, directora del departamento de Preparación Mundial de la OMS para Riesgos Infecciosos en conferencia de prensa.
“We are not in a pandemic yet. We are in an epidemic situation with multiple foci. There are currently 23 countries outside of China with reported cases. We are still very early in this outbreak.” World Health Organization @WHO provides an update on the #coronavirus outbreak. pic.twitter.com/pvIEGrjwDJ
— UN Geneva (@UNGeneva) February 4, 2020
Hasta el momento se han registrado 20 mil 704 casos en todo el mundo, 427 fallecidos y 664 recuperados. Al menos 20 mil 467 de los infectados se encuentran en China y 425 de las muertes también han sido en ese país.
Te puede interesar: Así construyó China hospital para coronavirus en sólo 10 días
Briand reconoció que el contagio de persona a persona es intenso y que por ello las autoridades chinas han tomado medidas para limitar su propagación.
Aceptó que el coronavirus originado en la ciudad china de Wuhan, es un gran “desafío” pero estimó posible detener la transmisión e incluso “eliminar este virus”.
Con información de Notimex.
sh